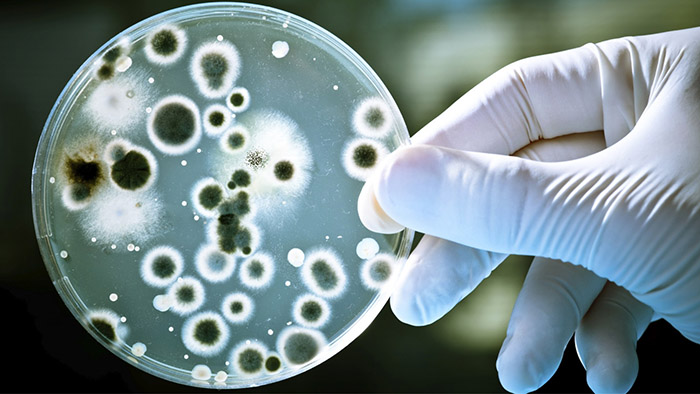

Nước thải chứa càng nhiều chất hữu cơ, chỉ số BOD và COD sẽ càng cao. Đồng nghĩa để giảm BOD và COD hệ thống cần loại bỏ các chất hữu cơ. Có nhiều phương pháp loại bỏ các chất hữu cơ, dưới đây là chi tiết.
Ý nghĩa chỉ số BOD và COD trong nước thải
Chỉ số BOD trong nước thải
BOD (viết tắt của Biochemical Oxygen Demand) là lượng oxy cần thiết để vi sinh vật phân hủy các chất hữu cơ dễ bị phân hủy sinh học trong nước thải, ở điều kiện hiếu khí (thường trong 5 ngày ở 20°C, gọi là BOD5). Đồng nghĩa, nếu thiếu oxy, vi sinh vật sẽ chết, cản trở quá trình xử lý nước thải.
Đơn vị: mg O2/L.
Ý nghĩa của chỉ số BOD:
- Phản ánh mức độ ô nhiễm hữu cơ của nước thải: BOD càng cao → càng nhiều chất hữu cơ → mức độ ô nhiễm càng lớn → nguy cơ gây hại cho môi trường nước (vì làm giảm lượng oxy hòa tan cần thiết cho sinh vật thủy sinh).
- Chỉ tiêu duy nhất xác định lượng chất hữu cơ có khả năng phân hủy sinh học.
- Cơ sở để chọn phương pháp xử lý, xác định kích thước thiết bị xử lý và hiệu quả xử lý.

Chỉ số COD trong nước thải
Chỉ số COD (viết tắt của Chemical Oxygen Demand) là lượng oxy cần thiết để oxy hoá các hợp chất hóa học trong nước (bao gồm cả vô cơ và hữu cơ).
Đơn vị: mg O2/L.
Ý nghĩa của chỉ số COD:
- Thể hiện tổng lượng chất hữu cơ (bao gồm cả dễ phân hủy và khó phân hủy sinh học) trong nước thải.
- COD thường cao hơn BOD, vì có cả các chất hữu cơ mà vi sinh vật không phân hủy được nhưng vẫn bị hóa chất oxy hóa.
Như vậy, BOD sẽ đo nhu cầu oxy do hoạt động vi sinh vật, là chỉ số phản ánh lượng chất hữu cơ dễ phân huỷ sinh học. Trong khi đó, COD sẽ đo nhu cầu oxy để oxy hóa hết chất hữu cơ, là chỉ số phản ánh tổng lượng chất hữu cơ (cả dễ và khó phân huỷ).
Cách giảm BOD trong nước thải
Chỉ số BOD chủ yếu phản ánh các chất hữu cơ dễ phân huỷ sinh học nên cách giảm BOD trong nước thải tối ưu nhất vẫn là phương pháp xử lý sinh học. Dưới đây là 3 cách giảm BOD cơ bản.
Cách giảm BOD trong quá trình xử lý sơ cấp
Trong quá trình sơ cấp, hệ thống có thể loại bỏ đến 30% BOD bằng phương pháp lắng. Tại đây chất rắn hữu cơ sẽ lắng xuống đáy và trở thành bùn. Do đó, trước khi vào xử lý thứ cấp, hệ thống cần có bể lắng sơ cấp nhằm giúp tăng hiệu suất cho quá trình xử lý.
Cách giảm BOD trong quá trình hiếu khí
BOD sẽ được loại bỏ nhờ vi sinh vật hiếu khí trong hệ thống xử lý bùn hoạt tính. Lúc này bể hiếu khí (Aerotank) sẽ đẩy mạnh quá trình sục khí oxy để quá trình phân huỷ của vi sinh vật diễn ra nhanh chóng, từ đó giảm BOD hiệu quả từ 80-95%.
Cách giảm BOD bằng quá trình kỵ khí
Trong bể kỵ khí (UASB, ABR), vi sinh vật kỵ khí sẽ phân huỷ chất hữu cơ thành khí CH4 và CO2, hiệu quả giảm BOD của quá trình này đạt khoảng 60-80%, thường áp dụng trước quá trình hiếu khí.

Cách giảm COD trong nước thải
Chỉ số COD thường khó xử lý hơn vì chứa cả chất hữu cơ khó phân huỷ sinh học, nhưng đồng thời sẽ có nhiều phương pháp xử lý. Để đạt hiệu quả tối ưu, hệ thống thường kết hợp nhiều phương pháp xử lý COD. Dưới đây là các phương pháp phổ biến.
Dùng hóa chất keo tụ
Để giảm COD trong nước thải, người ta thường dùng hoá chất keo tụ như PAC (Poly Aluminium Chloride), phèn, polymer để kết tủa chất hữu cơ khó phân hủy, chất keo. Bông cặn sẽ lắng xuống và được loại bỏ, từ đó giảm COD. Cách này giúp giảm COD trước hoặc sau công đoạn sinh học.

Dùng hóa chất oxy hóa
Để giảm COD có thể sử dụng các hoá chất oxy hoá như Clo, Hydrogen peroxide và Ozone. Quá trình Oxy hóa sẽ tách các chất ô nhiễm độc hại thành chất ít độc và tách chúng ra khỏi nước. Cách này thích hợp với nguồn nước ít chất hữu cơ, giàu chất không phân huỷ sinh học như phenol, chất hoạt động bề mặt,…
Dùng phản ứng Fenton
Phản ứng Fenton (Fe2+ + H2O2) là một phương pháp hóa học sử dụng tác nhân oxy hóa mạnh là gốc Hydroxyl để Oxy hóa các chất hữu cơ trong nước thải, chuyển hóa thành CO2 và nước, đồng thời làm giảm COD.
Dùng than hoạt tính để lọc và hấp phụ
Than hoạt tính, than gáo dừa, tro bay… được sử dụng để hấp phụ nhanh các chất hữu cơ khó phân hủy. Cách này không chỉ làm giảm COD mà còn giúp khử mùi, màu và nhiều hoá chất độc hại khác.
Dùng vi sinh vật
Ứng dụng vi sinh vật hiếu khí và kỵ khí để phân huỷ chất hữu cơ, từ đó giảm COD hiệu quả. Phương pháp này thường được ưu tiên sử dụng trước thay vì chỉ dùng hoá lý hoặc hóa chất vì các lý do sau:
- Hiệu quả cao (từ 85-90%).
- Thân thiện môi trường.
- Tiết kiệm chi phí.
- Xử lý được lưu lượng lớn và liên tục.
Men vi sinh giúp giảm BOD và COD trong nước thải hiệu quả
Một trong những sản phẩm ứng dụng vi sinh vật xử lý COD, BOD trong nước thải hiệu quả được sử dụng trong nhiều hệ thống hiện nay là men vi sinh Microbe-Lift IND. Sản phẩm thuộc thương hiệu men vi sinh hàng đầu Microbe-Lift, được nghiên cứu và sản xuất bởi công ty Ecological Laboratories.
Microbe-Lift IND là men vi sinh sở hữu đa dạng chủng vi sinh vật nhất trên thị trường với 13 chủng vi sinh chuyên biệt được nghiên cứu và ứng dụng công nghệ hàng đầu, cho hoạt tính mạnh gấp 5-10 lần vi sinh thông thường, phân huỷ được các hợp chất khó phân huỷ.
Bên cạnh đó, sản phẩm tồn tại ở dạng lỏng, kích hoạt nhanh, vi sinh thích nghi đa dạng môi trường, chịu được tải lượng cao. Chính vì những lý do này, sản phẩm được giới chuyên môn đánh giá rất cao.

Hiện nay, men vi sinh Microbe-Lift IND trở thành lựa chọn hàng đầu của nhiều hệ thống xử lý nước thải công nghiệp đến sinh hoạt, đô thị. Không chỉ là cứu tinh giúp giảm BOD, COD hiệu quả mà còn giải quyết được nhiều vấn đề về hệ thống xử lý nước thải. Giúp nước thải đầu ra đạt chuẩn, tiết kiệm thời gian, chi phí vận hành và nhân công.
Sản phẩm men vi sinh Microbe-Lift IND đang được BIOGENCY nhập khẩu và phân phối chính thức tại thị trường Việt Nam. Bên cạnh đó, BIOGENCY còn mang đến các giải pháp và kỹ thuật có tính ứng dụng trong thực tế đối với mỗi loại hình nước thải, giúp nâng cao hiệu quả và giải quyết triệt để vấn đề.
Để được hỗ trợ tư vấn chi tiết hơn về cách giảm BOD, COD trong nước thải bằng men vi sinh, đừng ngần ngại liên hệ ngay Hotline 0909 538 514.
>>> Xem thêm: [2025] Mức phạt khi xả nước thải vượt chuẩn ra môi trường mới nhất!


